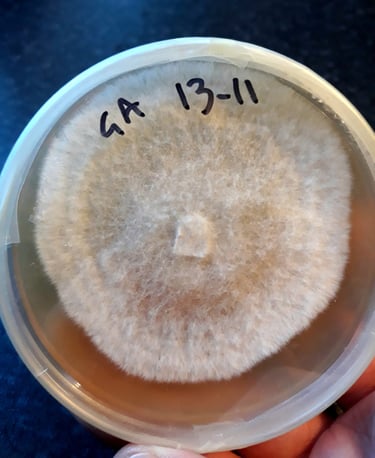
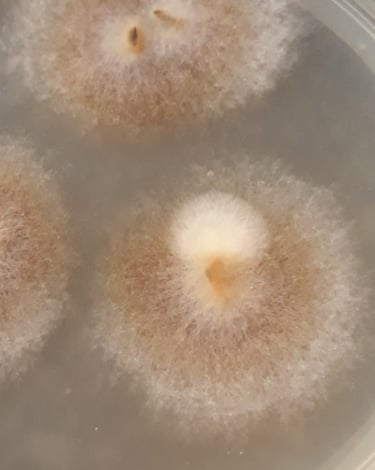
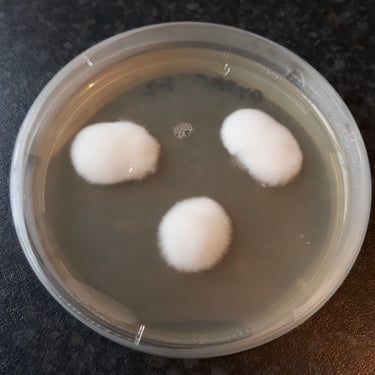
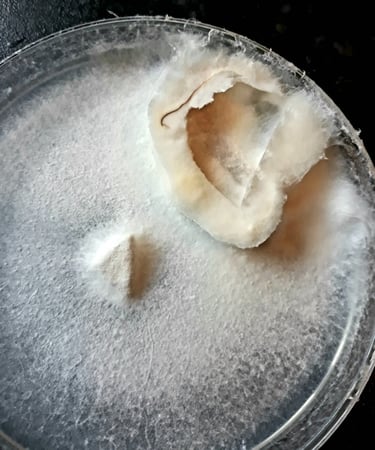
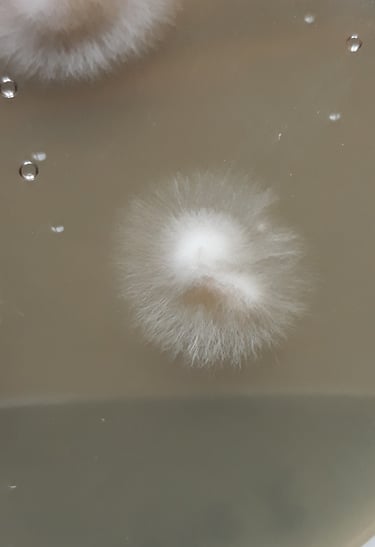
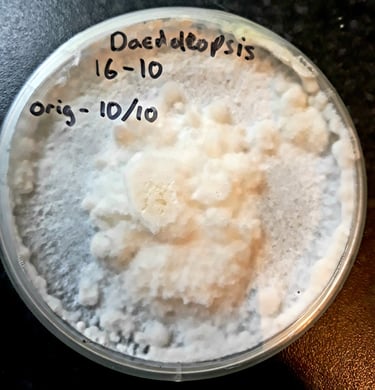
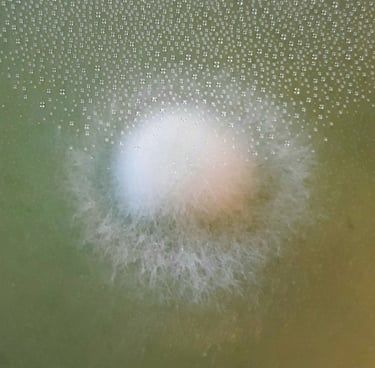
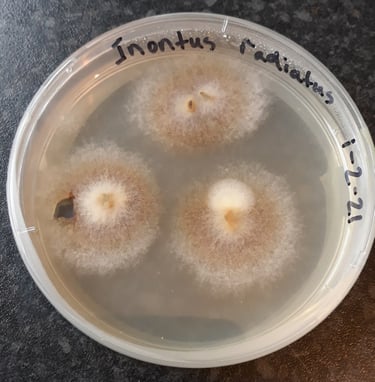
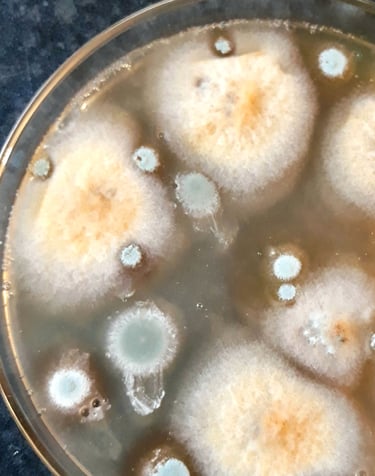

I received Arts Council England (DYCP) funding in August 2021 to develop clones of wild, British fungi which was cultured to explore mycelium as a sculptural and textile material. As the project developed I became increasingly interested in living fungi as fundamentally queer organisms which has led to a range of different projects examining their roles in the environment (Dirty Cultures) and their interaction with each other (CRYOphage) and other organisms. The following documents some of the research I've been doing and the organisms I'm working with. Check out my Instagram for much more @matthew.r.gale

Queer Biologies
Get in touch for collaborations and inquiries
© 2025. All rights reserved.